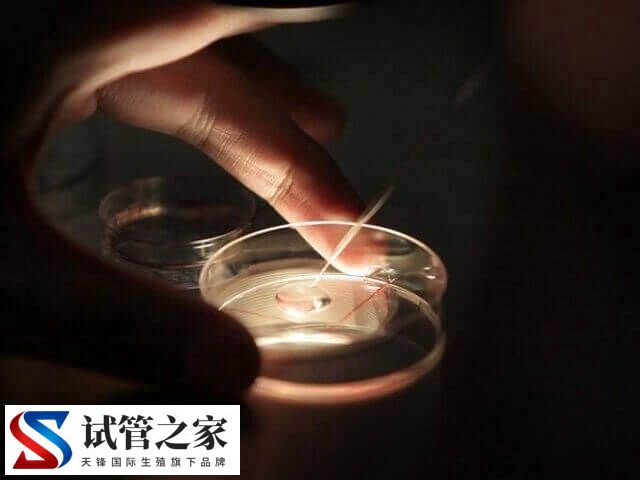
养囊6天了还没结果是好事还是坏事(图2) 养囊6天了还没结果是好事还是坏事(图2)

养囊6天了还没结果可能是好事,说明胚胎仍在继续发育,耐心等待即可养成囊胚,但也可能是坏事,毕竟迟迟未能发育成囊胚,那么就表明胚胎的内在质量存在差异,或者培养环境可能不是最适宜的。这时建议患者应该与生殖医生沟通,了解具体的胚胎情况和下一步的建议。

养囊6天了还能不能继续养
养囊是一个风险较高的过程,如果患者养囊六天了,仍然没有发育成熟,但活性较好,尝试继续培养到第七天继续观察,可能会有更好的结果。但如果囊胚在第6天已经显示发育停滞或质量不佳,那么继续培养的可能性较小,且不建议继续培养,以免浪费资源并增加风险。
对此建议建议养囊6天了,却还没有结果的患者,可以根据胚胎的具体情况和专家的建议来决定是否需要继续培养。在养囊的过程中,应保持积极的心态,同时遵循专业医生的指导。
养囊6天了还没结果怎么回事
养囊6天了还没有养成囊胚可能是好事还是坏事,这取决于多个因素,包括胚胎的发育速度、活性以及母体和精子的健康状况等。
1、卵子和精子的质量
卵子和精子的质量对囊胚的形成至关重要。如果卵子不成熟或精子质量不佳(如精子活力不足、精子畸形率高等),都会影响受精和胚胎的质量,进而影响囊胚的形成,进而导致养囊6天了还没结果。
2、胚胎发育问题
并非所有的胚胎都能形成囊胚。如果胚胎质量不好,例如存在染色体异常或胚胎发育缓慢,这也会影响到囊胚的形成。
3、实验室条件
不同的生殖中心实验室技术和经验有所不同,这对养囊的成功率有很大影响。实验室的设备先进程度、操作技术的熟练度等都会影响到最终的结果。
4、线粒体数量
研究表明,胚胎中线粒体的含量影响囊胚的形成和质量。如果养囊失败,可能是由于线粒体数量不足导致的。此外,高精子DNA碎片率可能导致胚胎延迟分裂,从而影响胚胎质量和养囊的成功率。





